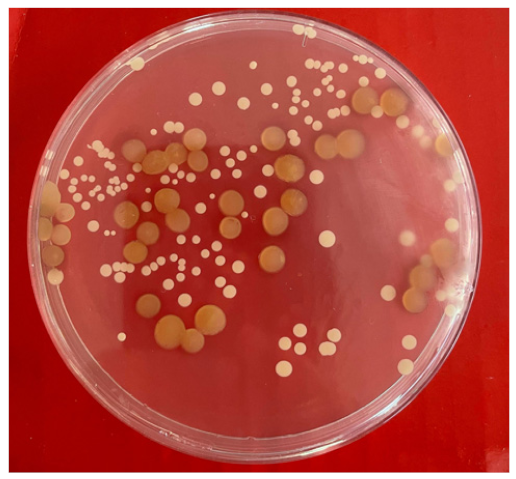

Application of Co-Culture Technology to Enhance Protease Production by Two Halophilic Bacteria, Marinirhabdus sp. and Marinobacter hydrocarbonoclasticus
Abstract
1. Introduction
- The substrate used is defined and constant.
- The conditions of operation of the microbial product are stringent and consistent.
- The products are of significant commercial value.
2. Results
2.1. Bacteria Growth and Protease Activity—Comparison of Mono and Co-Cultures
2.2. Effect of pH, Temperature, and Salinity on Protease Activity
3. Discussion
4. Materials and Methods
4.1. Reagents and Equipment
4.2. Bacteria
4.3. Culture Conditions
4.4. Enzyme Preparations
4.5. Effect of pH, Temperature, and Salinity on Protease Activity in Mono and Mixed Culture
4.6. Statistical Methods
5. Conclusions
Author Contributions
Funding
Conflicts of Interest
Sample Availability
References
- Grunwald, P. Mixed Microbial Cultures for Industrial Biotechnology: Success, Chance, and Challenges; Pan Stanford: Singapore, 2015. [Google Scholar]
- Sabir, S.; Bhatti, H.N.; Zia, M.A.; Sheikh, M.A. Enhanced production of glucose oxidase using Penicillium notatum and rice polish. Food Technol. Biotechnol. 2007, 45, 443–446. [Google Scholar]
- Asgher, M.; Asad, M.J.; Rahman, S.U.; Legge, R.L. A thermostable α-amylase from a moderately thermophilic Bacillus subtilis strain for starch processing. J. Food Eng. 2007, 79, 950–955. [Google Scholar] [CrossRef]
- Liu, D. Chapter 61-Aeromonas. In Molecular Medical Microbiology, 2nd ed.; Tang, Y.-W., Sussman, M., Liu, D., Poxton, I., Schwartzman, J., Eds.; Academic Press: Boston, MA, USA, 2015. [Google Scholar]
- Singh, A.; Singh, A.K. Isolation, characterization and exploring biotechnological potential of halophilic archaea from salterns of western India. 3 Biotech 2018, 8, 45. [Google Scholar] [CrossRef] [PubMed]
- Liang, Y.; Cheng, X.; Zhu, H.; Shutes, B.; Yan, B.; Zhou, Q.; Yu, X. Historical Evolution of Mariculture in China During Past 40 Years and Its Impacts on Eco-environment. Chin. Geogr. Sci. 2018, 28, 363–373. [Google Scholar] [CrossRef]
- Wang, X.; Zhu, H.; Yan, B.; Shutes, B.; Bañuelos, G.; Wen, H. Bioaugmented constructed wetlands for denitrification of saline wastewater: A boost for both microorganisms and plants. Environ. Int. 2020, 138, 105628. [Google Scholar] [CrossRef] [PubMed]
- FAO. Water Pollution from Agriculture: A Global Review. 2017. Available online: http://www.fao.org/3/i7754e/i7754e.pdf (accessed on 4 May 2021).
- Dalsgaard, J.; Lund, I.; Thorarinsdottir, R.; Drengstig, A.; Arvonen, K.; Pedersen, P.B. Farming different species in RAS in Nordic countries: Current status and future perspectives. Aquac. Eng. 2013, 53, 2–13. [Google Scholar] [CrossRef]
- Ching, Y.C.; Redzwan, G. Biological Treatment of Fish Processing Saline Wastewater for Reuse as Liquid Fertilizer. Sustainability 2017, 9, 1062. [Google Scholar] [CrossRef]
- Land, T.M.S.; Veit, M.T.; Cunha, D.A.; Gonçalves, G.; Palácio, S.M.; Barbieri, J.C.Z.; Oliveira, D.; Nascimento, C.; Campos, E.G.P. Evaluation of a Coagulation/Flocculation Process as the Primary Treatment of Fish Processing Industry Wastewater. Water Air Soil Pollut. 2020, 231, 452–464. [Google Scholar] [CrossRef]
- Cristóvão, R.O.; Botelho, C.M.; Martins, R.J.; Loureiro, J.M.; Boaventura, R.A. Primary treatment optimization of a fish canning wastewater from a Portuguese plant. Water Resour. Ind. 2014, 6, 51–63. [Google Scholar] [CrossRef]
- Wen, J.; Dong, H.; Zeng, G. Application of zeolite in removing salinity/sodicity from wastewater: A review of mechanisms, challenges and opportunities. J. Clean. Prod. 2018, 197, 1435–1446. [Google Scholar] [CrossRef]
- Méndez, R.; Omil, F.; Soto, M.; Lema, J.M. Pilot Plant Studies on the Anaerobic Treatment of Different Wastewaters from a Fish-Canning Factory. Water Sci. Technol. 1992, 25, 37–44. [Google Scholar] [CrossRef]
- Balslev-Olesen, P.; Lynggaard-Jensen, A.; Nickelsen, C. Pilot-Scale Experiments on Anaerobic Treatment of Wastewater from a Fish Processing Plant. Water Sci. Technol. 1990, 22, 463–474. [Google Scholar] [CrossRef]
- Dan, N.; Visvanathan, C.; Basu, B. Comparative evaluation of yeast and bacterial treatment of high salinity wastewater based on biokinetic coefficients. Bioresour. Technol. 2003, 87, 51–56. [Google Scholar] [CrossRef]
- Jamieson, B.L.; Gonçalves, A.A.; Gagnon, G.A. Toxicology evaluation of Atlantic Canadian seafood processing plant effluent. Environ. Toxicol. 2009, 25, 137–146. [Google Scholar] [CrossRef]
- Tun, L.; Hlaing, S. Physico-Chemical Process for Fish Processing Wastewater Treatment. In Proceedings of the 10th Regional Conference on Chemical Engineering, Manila, Philippines, 6–7 November 2017. [Google Scholar]
- Jana, B.B.; Jayasankar, P.; Mandal, N.R. Wastewater Management through Aquaculture; Springer: Singapore, 2018. [Google Scholar]
- Griffiths, B.S.; Philippot, L. Insights into the resistance and resilience of the soil microbial community. FEMS Microbiol. Rev. 2013, 37, 112–129. [Google Scholar] [CrossRef]
- Shade, A.; Peter, H.; Allison, S.D.; Baho, D.L.; Berga, M.; Buergmann, H.; Huber, D.H.; Langenheder, S.; Lennon, J.T.; Martiny, J.B.H.; et al. Fundamentals of Microbial Community Resistance and Resilience. Front. Microbiol. 2012, 3, 417. [Google Scholar] [CrossRef]
- Bizukojc, M.; Dietz, D.; Sun, J.; Zeng, A.-P. Metabolic modelling of syntrophic-like growth of a 1,3-propanediol producer, Clostridium butyricum, and a methanogenic archeon, Methanosarcina mazei, under anaerobic conditions. Bioprocess Biosyst. Eng. 2009, 33, 507–523. [Google Scholar] [CrossRef]
- Santala, S.; Karp, M.; Santala, V. Rationally Engineered Synthetic Coculture for Improved Biomass and Product Formation. PLoS ONE 2014, 9, e113786. [Google Scholar] [CrossRef]
- Anh, H.T.H.; Shahsavari, E.; Bott, N.J.; Ball, A.S. Bioaugmentation of seafood processing wastewater enhances the removal of inorganic nitrogen and chemical oxygen demand. Aquaculture 2021, 542, 736818. [Google Scholar] [CrossRef]
- Anh, H.T.H.; Shahsavari, E.; Bott, N.J.; Ball, A.S. The application of Marinobacter hydrocarbonoclasticus as a bioaugmentation agent for the enhanced treatment of non-sterile fish wastewater. J. Environ. Manag. 2021, 291, 112658. [Google Scholar] [CrossRef]
- Zhou, J.; Ma, Q.; Yi, H.; Wang, L.; Song, H.; Yuan, Y.-J. Metabolome Profiling Reveals Metabolic Cooperation between Bacillus megaterium and Ketogulonicigenium vulgare during Induced Swarm Motility. Appl. Environ. Microbiol. 2011, 77, 7023–7030. [Google Scholar] [CrossRef] [PubMed]
- Singh, R.; Kumar, M.; Mittal, A.; Mehta, P.K. Microbial enzymes: Industrial progress in 21st century. 3 Biotech 2016, 6, 1–15. [Google Scholar] [CrossRef] [PubMed]
- Zhang, H.; Pereira, B.; Li, Z.; Stephanopoulos, G. Engineering Escherichia coli coculture systems for the production of biochemical products. Proc. Natl. Acad. Sci. USA 2015, 112, 8266–8271. [Google Scholar] [CrossRef] [PubMed]
- Liu, Y.; Ding, M.; Ling, W.; Yang, Y.; Zhou, X.; Li, B.-Z.; Chen, T.; Nie, Y.; Wang, M.; Zeng, B.; et al. A three-species microbial consortium for power generation. Energy Environ. Sci. 2017, 10, 1600–1609. [Google Scholar] [CrossRef]
- Wintermute, E.H.; Silver, P.A. Emergent cooperation in microbial metabolism. Mol. Syst. Biol. 2010, 6, 407. [Google Scholar] [CrossRef] [PubMed]
- Flint, H.J.; Duncan, S.H.; Scott, K.P.; Louis, P. Interactions and competition within the microbial community of the human colon: Links between diet and health. Environ. Microbiol. 2007, 9, 1101–1111. [Google Scholar] [CrossRef] [PubMed]
- Teng, Y.; Luo, Y.; Sun, M.; Liu, Z.; Li, Z.; Christie, P. Effect of bioaugmentation by Paracoccus sp. strain HPD-2 on the soil microbial community and removal of polycyclic aromatic hydrocarbons from an aged contaminated soil. Bioresour. Technol. 2010, 101, 3437–3443. [Google Scholar] [CrossRef]
- Bhaskar, N.; Sudeepa, E.; Rashmi, H.; Selvi, A.T. Partial purification and characterization of protease of Bacillus proteolyticus CFR3001 isolated from fish processing waste and its antibacterial activities. Bioresour. Technol. 2007, 98, 2758–2764. [Google Scholar] [CrossRef]
- Xu, Y.; Lv, J.; Xie, C.; Sun, S.; Ke, L.; Chen, S. Halorubrum glutamatedens sp. nov., a Halophilic Archaeon Isolated from a Rock Salt. Curr. Microbiol. 2018, 76, 52–56. [Google Scholar] [CrossRef]
- Mehdi, H.; Jafar, M. Isolation and characterization of Halobacterium salinarum from saline lakes in Iran. Jundishapur J. Microbiol. 2011, 4, S59. [Google Scholar]
- Benson, H.J. Microbiological Applications: Laboratory Manual in General Microbiology; WCB/McGraw-Hill: Boston, MA, USA, 1998. [Google Scholar]
- Dworkin, M.; Falkow, S.; Rosenberg, E.; Schleifer, K.-H.; Stackebrandt, E. The Myxobacteria; Springer: New York, NY, USA, 2007. [Google Scholar]
- Sigmaaldrich. 2021. Available online: https://www.sigmaaldrich.com/catalog/product/sial/76448?lang=en®ion=AU&gclid=CjwKCAjw7J6EBhBDEiwA5UUM2pKzVVPu8EG9XhGalAvQ1ofCU2gaG8EobWxvwK7bdMxdgzGwSGXkcRoCbqwQAvD_BwE (accessed on 27 April 2021).
- Green, L.H.; Goldman, E. Practical Handbook of Microbiology; CRC Press: Boca Raton, FL, USA, 2008. [Google Scholar]
- Ball, A.S.; Mccarthy, A.J. Sacchariiication of Straw by Actinomycete Enzymes. Microbiology 1988, 134, 2139–2147. [Google Scholar] [CrossRef][Green Version]
- Ebihara, A.; Kawamoto, S.; Shibata, N.; Yamaguchi, T.; Suzuki, F.; Nakagawa, T. Development of a modified Britton-Robinson buffer with improved linearity in the alkaline pH region. Bioj. Sci. Technol. 2016, 3, 7–16. [Google Scholar]


| Bacteria | Image of the Colony | Distinguishing Characteristics |
|---|---|---|
| Marinihabdus sp. | ![]() | Circular shape; moderate and large size (>3 mm in diameter). Shiny and smooth surface; Light yellow color and the margin is entire. |
| Marinobacter sp. | ![]() | Circular shape; small and medium size (1–3 mm in diameter). Opaque and rough surface; milk-white color, and the margin is curled. |
| Number of colonies of Marinihabdus sp. and Marinobacter sp. (cells·mL−1) in co-culture at dilution 10−5 | ![]() | Marinihabdus sp.: 4.1 × 106 (cells·mL−1) Marinobacter sp.: 11.6 × 106 (cells·mL−1) |
| Sample | Biomass (OD600) | Effect of Temperature on Protease Activity | Effect of pH on Protease Activity | Effect of Salinity on Protease Activity | |||
|---|---|---|---|---|---|---|---|
| Optimum Temperature * (to) | Protease Activity (Units·OD−1) | Optimum Ph * | Protease Activity (Units OD−1) | Optimum Salinity * (%) | Protease Activity (Units·OD−1) | ||
| Marinihabdus | 0.788 | 30–45 | 6.3–19.2 | 4–8 | 8.8–21.2 | 5–15 | 10.5–19.5 |
| Marinobacter | 0.960 | 45–60 | 13.4–22.3 | 8–12 | 4.8–19.4 | 20–30 | 10.9–16.1 |
| Co-culture | 1.398 | 25–60 | 22.1–34.2 | 4–12 | 19.4–34.5 | 10–30 | 14.0–24.7 |
Publisher’s Note: MDPI stays neutral with regard to jurisdictional claims in published maps and institutional affiliations. |
© 2021 by the authors. Licensee MDPI, Basel, Switzerland. This article is an open access article distributed under the terms and conditions of the Creative Commons Attribution (CC BY) license (https://creativecommons.org/licenses/by/4.0/).
Share and Cite
Anh, H.T.H.; Shahsavari, E.; Bott, N.J.; Ball, A.S. Application of Co-Culture Technology to Enhance Protease Production by Two Halophilic Bacteria, Marinirhabdus sp. and Marinobacter hydrocarbonoclasticus. Molecules 2021, 26, 3141. https://doi.org/10.3390/molecules26113141
Anh HTH, Shahsavari E, Bott NJ, Ball AS. Application of Co-Culture Technology to Enhance Protease Production by Two Halophilic Bacteria, Marinirhabdus sp. and Marinobacter hydrocarbonoclasticus. Molecules. 2021; 26(11):3141. https://doi.org/10.3390/molecules26113141
Chicago/Turabian StyleAnh, Hoang Thi Hong, Esmaeil Shahsavari, Nathan J. Bott, and Andrew S. Ball. 2021. "Application of Co-Culture Technology to Enhance Protease Production by Two Halophilic Bacteria, Marinirhabdus sp. and Marinobacter hydrocarbonoclasticus" Molecules 26, no. 11: 3141. https://doi.org/10.3390/molecules26113141
APA StyleAnh, H. T. H., Shahsavari, E., Bott, N. J., & Ball, A. S. (2021). Application of Co-Culture Technology to Enhance Protease Production by Two Halophilic Bacteria, Marinirhabdus sp. and Marinobacter hydrocarbonoclasticus. Molecules, 26(11), 3141. https://doi.org/10.3390/molecules26113141